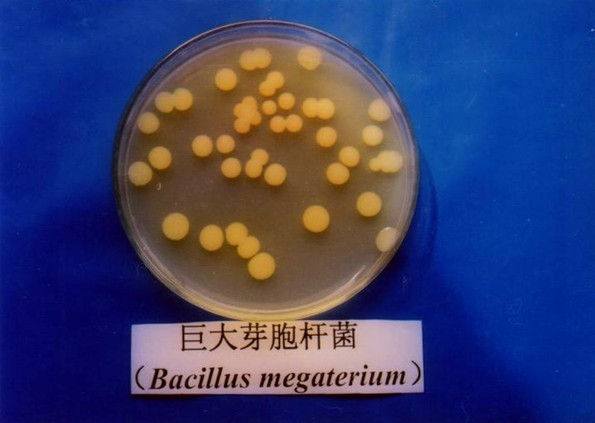
p>巨大芽孢杆菌( i>bacillus megaterium /i> de bary,1884):杆状

巨大芽孢杆菌图片

巨大芽孢杆菌细菌
图片尺寸570x375
巨大芽孢杆菌及其在处理重金属62草甘膦复合污染中应用的制造方法与
图片尺寸1000x939
巨大芽孢杆菌生防作用
图片尺寸800x1066p>巨大芽孢杆菌( i>bacillus megaterium /i> de bary,1884):杆状
图片尺寸595x423
枯草,解淀粉,巨大等芽孢杆菌,平板图片##微生物菌剂 #益昊 - 抖音
图片尺寸1374x1280
芽孢杆菌
图片尺寸1200x784![[分享] 芽孢图片](https://imgs.wantubizhi.com/img/A1A61BAA66193547F3A6DD7D8EE527E9C9565FBF8BD8E398DB6CA7418FC38D0BDE715A7F44335CDAF73903B8587929CB00CBFC53C29D2689468433C04F292E5847DF747061F8CD6BC49631FA30772DF8462A136CE80852CE554B0B9588A29BB1)
[分享] 芽孢图片
图片尺寸3264x1836
厂家巨大芽孢杆菌提高并延长肥效减少化学肥料
图片尺寸1920x1440
巨大芽孢杆菌_北纳生物bncc194581_技术参数_价格-仪器网
图片尺寸371x216
芽胞杆菌工程化实验室简介 - 芽孢杆菌生产性实验室
图片尺寸2272x1514
海洋巨大芽孢杆菌,微生物肥料及发酵液和应用
图片尺寸1000x943
带你认识枯草芽孢杆菌
图片尺寸720x534
一株贝莱斯芽孢杆菌及其在香梨病害防治中的应用
图片尺寸472x468
芽孢杆菌
图片尺寸754x1008
这个是芽孢杆菌吗?
图片尺寸1968x2624
巨大芽孢杆菌
图片尺寸500x375
纳豆芽孢杆菌菌农学
图片尺寸500x500
巨大芽孢杆菌的菌落形态
图片尺寸1890x1476
芽孢杆菌
图片尺寸559x420
巨大芽孢杆菌
图片尺寸320x310
猜你喜欢:芽孢杆菌图片显微镜苏云金芽孢杆菌图片芽孢杆菌图片胶质芽孢杆菌巨大芽孢杆菌枯草芽孢杆菌图片巨大芽孢杆菌芽孢绘图巨大芽孢杆菌芽孢染色芽孢杆菌菌落图片芽孢杆菌图片高清地衣芽孢杆菌图片巨大芽孢杆菌形态图芽孢杆菌图片手绘图蜡样芽孢杆菌图片炭疽芽孢杆菌图片巨大芽孢杆菌除臭凝结芽孢杆菌活菌片侧孢芽孢杆菌芽孢杆菌显微镜下图片蜡样芽孢杆菌片芽孢杆菌贝莱斯芽孢杆菌芽孢杆菌手绘图蕈状芽孢杆菌凝结芽孢杆菌地衣芽孢杆菌短小芽孢杆菌地衣芽孢杆菌活菌颗粒地衣芽孢杆菌活菌胶囊蜡样芽孢杆菌活菌胶囊夏洛特·斯慕吉彩色贾斯汀马斯克施工现场六牌一图内容止逆阀安装兔子闹钟怎么画花子君图片 小樱中式拖尾qq飞车宣传杜淳老婆谁野稻窗帘马克笔手绘宋伟杰演员图片

![[分享] 芽孢图片](https://file3.foodmate.net/attachment/forum/201212/21/164745er8jjmnmj8x8jzjr.jpg)












